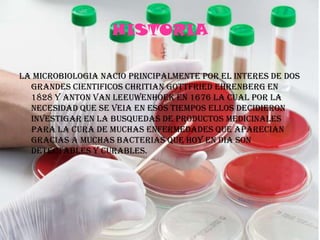
HISTORIA LA MICROBIOLOGIA NACIO PRINCIPALMENTE POR EL INTERES DE DOS GRANDES CIENTIFICOS CHRITIAN GOTTFRIED EHRENBERG EN 1828 Y ANTON VAN LEEUWENHOEK EN 1676 LA CUAL POR LA NECESIDAD QUE SE VEIA EN ESOS TIEMPOS ELLOS DECIDIERON INVESTIGAR EN LA BUSQUEDAS DE PRODUCTOS MEDICINALES PARA LA CURA DE MUCHAS ENFERMEDADES QUE APARECIAN GRACIAS A MUCHAS BACTERIAS QUE HOY EN DIA SON DETECTABLES Y CURABLES.
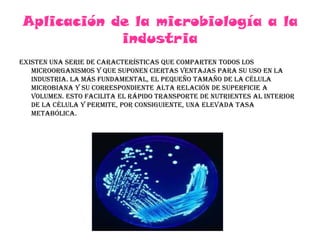
Aplicación de la microbiología a la industriaExisten una serie de características que comparten todos los microorganismos y que suponen ciertas ventajas para su uso en la industria. la más fundamental, el pequeño tamaño de la célula microbiana y su correspondiente alta relación de superficie a volumen. Esto facilita el rápido transporte de nutrientes al interior de la célula y permite, por consiguiente, una elevada tasa metabólica.

Este documento resume la microbiología como el estudio de microorganismos como bacterias, hongos y protistas que no se pueden ver a simple vista. Explica que la microbiología surgió en el siglo XVII gracias al trabajo de científicos como Anton van Leeuwenhoek, Louis Pasteur y Robert Koch. Además, detalla algunos descubrimientos clave en microbiología y sus aplicaciones en medicina, industria y agricultura.